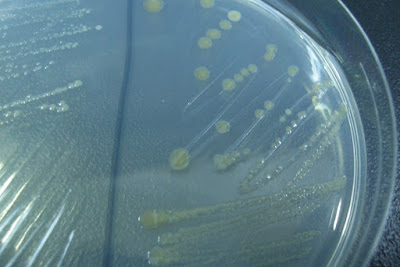

三千弱水,只要一瓢!?
「寶玉呆了半晌,忽然大笑道:『任憑弱水三千,我只取一瓢飲。』」
林黛玉:表示……
薛寶釵:……
這是曹雪芹在紅樓夢中,描述賈寶玉只愛唯一的情節。賈的專情並不是本文所關注的重點,一瓢弱水的生命內涵是什麼?才是微生物工作者想要知道的。
細菌培養
我們都知道這一瓢海水裏有細菌,但人的肉眼看不到,如何把它們從海水中挑出來,進行培養?一般而言,細菌的培養包含幾個工作:
- 培養基製作:預先擬定研究的目標菌種,根據菌種特性設計培養基。
- 分離菌株:利用培養基,將細菌從環境(海水、底泥、鹽沼等)中分離(挑)出來。這個把細菌挑出來培養的過程,學界術語稱作:分離(isolating)。
- 純化培養:確認所分離之菌株為純系,才會進一步執行相關的試驗。
![]() |
| 分離菌株的最簡單方法一般會用平版培養基,讓細菌在上面生長成一顆顆菌落 (基本上一隻細菌會進行細胞分裂,最後聚集成為一個肉眼可以見到的菌落)。 |
分離菌株實際操作方法與步驟如下:
- 準備培養基:包括(緩衝)稀釋液和平板(洋菜)培養基。
- 採樣:到海邊去,取一瓢(桶、瓶、罐、壺等等等…都可以)海水回來。
- 利用(緩衝)稀釋液,將海水以10的倍率多個階段稀釋。(為什麼要稀釋10倍…..1000倍….?)
- 將不同倍率稀釋後的海水,各取約0.1 mL,均勻塗抹於平板培養基上,放置於25~30度的恆溫箱中培養。
- 培養數日後,平板培養基上會出現大大小小不同形態和顏色的菌落,挑選您合意的菌落,用連續劃線法加以純化,確認為純菌後,接種於高層培養基中,並置於20℃恆溫箱中行繼代保存;繼代保存每三~四個月進行一次。
您如果想要在茫茫大海中,找到那一個唯一最愛的菌種,除了運氣外,培養基的設計將會大大提升成功的機會。(至於怎設計?待咱另回分解!)
題外:弱水在那兒?
《海內十洲記》記載:鳳麟洲在西海之中央,地方一千五百里。洲四面有弱水繞之,鴻毛不浮,不可越也。洲上多鳳麟,數萬各為群。又有山川池澤,及神藥百種,亦多仙家。
請先 登入 以發表留言。